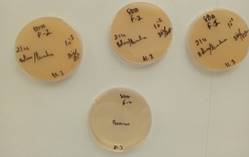

Ciencia & Futuro
V. 15. No.3 septiembre-noviembre 2025
ISSN: 2306-823X
Recibido: 1/6/2025/Aceptado: 19/7/2025
Evaluation of the Use of Residual Brine from Sea Salt Production in the Lactic Fermentation of Carrots
Evaluación del uso de salmuera residual procedente de la producción de sal marina en la fermentación láctica de zanahorias
Esnaider Rodríguez Suárez erodriguezsuarez2013@gmail.com (1)
https://orcid.org/0009-0001-8615-3259
Aive Amélia Vasco Mate aivemate009@gmail.com (1)
https://orcid.org/0009-0007-1734-0406
(1) Wutivi-UniTiva University, Boane, Maputo, Mozambique
Abstract: This study assesses the feasibility of using residual brine from Salinas Golfinho, Lda, as an alternative medium for the lactic fermentation of carrots (Daucus carota L.). Physico-chemical, microbiological and sensory studies were carried out. The residual brine had a pH of 6.0, a hardness of 290 mg/L (expressed as CaCO3), a chloride concentration of 5 %, and no phosphorus or nitrates. After heat treatment and concentration, it was applied to the spontaneous fermentation of carrots for 15 days. The final product had a pH between 3.5 and 3.9, a mold count of 0 UFC/g and yeast counts of over 300 UFC/g, suggesting possible parallel alcoholic fermentation associated with the active presence of yeast. The centesimal analysis showed an increase in moisture from 90 % to 92 %, in ash from 0.7% to 1.1%, in fiber from 2.5 % to 2.8 % and in calcium from 33 mg/100 g to 48 mg/100 g compared to fresh carrots. At the same time, there was a reduction in carbohydrates from 5.6% to 2.9% and in the energy value from 26 kcal/100 g to 17.3 kcal/100 g and phosphorus from 30 mg/100 g to 23 mg/100 g. The sensory analysis revealed good acceptance, especially in terms of texture, aroma and flavor, with the final product being described as similar to fermented olives. The study concludes that residual brine is technically viable as a fermentation medium, capable of improving the nutritional profile of carrots.
Keywords: food safety, food engineering, vegetable preservation
Resumen: Este estudio evalúa la viabilidad de utilizar la salmuera residual procedente de la Salina Golfinho, Lda, como medio alternativo para la fermentación láctica de zanahorias (Daucus carota L.). Se realizaron estudios físico-químicos, microbiológicos y sensoriales. La salmuera residual tenía un pH de 6,0, una dureza de 290 mg/L (expresada como CaCO3), una concentración de cloruro del 5% y no contenía fósforo ni nitratos. Tras el tratamiento térmico y la concentración, se aplicó a la fermentación espontánea de zanahorias durante 15 días. El producto final tenía un pH de entre 3,5 y 3,9, un recuento de mohos de 0 UFC/g y recuentos de levaduras de más de 300 UFC/g, lo que sugiere una posible fermentación alcohólica paralela asociada a la presencia activa de levaduras. El análisis centesimal mostró un aumento de la humedad del 90% al 92%, de las cenizas del 0,7% al 1,1%, de la fibra del 2,5% al 2,8% y del calcio de 33 mg/100 g a 48 mg/100 g en comparación con las zanahorias frescas. Al mismo tiempo, se produjo una reducción de los hidratos de carbono del 5,6% al 2,9% y del valor energético de 26 kcal/100 g a 17,3 kcal/100 g y del fósforo de 30 mg/100 g a 23 mg/100 g. El análisis sensorial reveló una buena aceptación, especialmente en términos de textura, aroma y sabor, describiéndose el producto final como similar a las aceitunas fermentadas. El estudio concluye que la salmuera residual es técnicamente viable como medio de fermentación, capaz de mejorar el perfil nutricional de las zanahorias.
Palabras clave: conservación de vegetales, seguridad alimentaria, ingeniería de los alimentos
Introduction
Preserving vegetables and fruit through fermentation is an ancient practice that combines nutritional and sensory benefits with greater food durability. Lactic fermentation stands out as one of the most traditional and natural methods of preservation, dispensing with chemical additives (Katz & Tanguy, 2023). Furthermore, innovation in this process has become essential to guarantee quality and sustainability in the food industry. This work proposes the use of residual brine from sea salt production in the fermentation of vegetables and fruit, promoting the use of industrial by-products to create sustainable and innovative foods.
The production of sea salt results in the formation of salt crystals and the generation of residual brine, a solution rich in minerals and salts that is often discarded. However, when treated properly, this brine can be used as an alternative to conventional salt in fermentation, in line with circular economy and environmental sustainability practices. This utilization not only reduces waste, but can also enrich fermented foods with additional nutrients.
Lactic fermentation, driven by the salt present in the brine, is a natural process in which microorganisms convert sugars into lactic acid, preserving food and improving its digestibility (Didari et al., 2014). As well as increasing food safety and extending the shelf life of vegetables, fermentation reduces anti-nutritional compounds such as phytates and improves the bioavailability of essential minerals such as iron and calcium (Ray & Sivakumar, 2009). The use of residual brine can therefore enhance these benefits and contribute to the supply of probiotic foods with a positive impact on intestinal health (Zapasnik, Sokolowska & Bryla, 2022; Valentino et al., 2024; Abbaspour, 2024).
In hot climate regions, where food deterioration is accelerated, fermentation with residual brine can be a viable alternative for preserving out-of-season vegetables and fruit, as well as allowing the use of products that, for aesthetic reasons, would not be marketed, but still have high nutritional value (Sharma et al., 2015). This approach is especially relevant in developing countries, where conventional methods such as freezing and canning can be economically unviable and susceptible to preservation failures (Huang et al., 2023).
The growing interest in fermented foods, recognized for their benefits to the intestinal microbiota and disease prevention, reinforces the relevance of this research. These products are rich in antioxidants, such as flavonoids and carotenoids, which play a key role in the prevention of degenerative diseases and healthy ageing (Kaur & Kapoor, 2017). Thus, the development of fermented preserves with residual brine responds to a demand for healthier and more natural foods.
This study will assess the feasibility and benefits of using residual brine in carrot fermentation, considering aspects such as sensory quality, food safety and sustainability. By encouraging the use of industrial by-products in the production of affordable and nutritious food, this research contributes to innovative solutions in food preservation. In addition, the study is part of the broader context of food innovation, exploring lactic fermentation as a sustainable approach that combines tradition and technology in the production of healthy and ecological food.
Presentation and definition of the research problem
The growing concern about post-harvest losses and food waste represents one of the main challenges facing the global agri-food chain. a significant proportion of vegetables, such as carrots, are discarded before they even reach the end consumer, compromising not only food safety, but also the resources invested along the production chain (Fernández-Xicoten, 2023). At the same time, another highly relevant environmental problem is the disposal of the residual brine generated in the production of sea salt, a by-product highly concentrated in salts, the improper disposal of which can have negative impacts on ecosystems, water quality and soils.
The final destination of waste brine, when not treated appropriately, is an environmental threat and can contribute to the salinization of agricultural land, the degradation of aquatic biodiversity and the contamination of groundwater. In addition to the environmental impact, this problem also has social and humanitarian implications, given that food waste and the unsustainable use of natural resources occur alongside realities of food insecurity in various communities.
The objective of this research is to evaluate the feasibility of reusing residual brine from the sea salt industry as an alternative medium for the lactic fermentation of vegetables, with a focus on the production of lacto-fermented carrots.
Materials and method
Characterization of the research
This study adopts a mixed methods approach, combining quantitative and qualitative methods to evaluate the feasibility of using residual brine to preserve carrots. The research is of an applied nature, as it seeks to develop a practical solution for using brine in vegetable fermentation (Marconi & Lakatos, 2017). It is also exploratory in nature, as it investigates a little-studied application of this by-product, allowing for the formulation of new hypotheses about its use (Sousa, Oliveira & Alves, 2021).
The methodological procedures include bibliographical research, experimental research and field research. Bibliographic research is based on a literature review on residual brine, lactic fermentation and vegetable preservation (Boccato, 2006). Experimental research involves collecting samples, fermenting the carrots and carrying out laboratory analyses to characterize the effects of the brine on the quality of the final product (Gil, 2008). Field research consists of obtaining the residual brine from Salinas Golfinho, Lda and analyzing the local Fajardo market in Maputo, helping to contextualize the experimental data in a real scenario.
General description of the salt company under study Salinas Golfinho, Lda
Salina Golfinho, Lda were founded in 2009, with the main objective of producing sea salt in an artisanal way. The company operates two production units located in Maputo Province: the head office in Matola “A” and a branch in Chinonanquila/Campoane. The saltworks are located downstream from a residential area, which requires special attention to the environmental management of the waste generated.
Structural Features and Spatial Organization: The salt pan occupies an estimated total area of around 5 hectares, with a functional layout of structures. It has approximately 28 evaporation tanks, each with an average area of 20 m², organized in rows connected by water conduction channels. There are also around 8 shallow crystallizers, varying in size, for precipitating salt crystals. The infrastructure also includes 1 storage warehouse, 1 administrative office and 1 machine room.
Sea salt production process: Production begins with the collection of seawater during high tide, led to primary reservoirs with a capacity of around 10,000 liters. The water goes to settling tanks, where the solid particles are sedimented. The water is then directed to the evaporation tanks, where it gradually loses volume due to the action of the sun and wind, until it reaches a high saline concentration. In the crystallizers, the salt crystals precipitate. The first product collected is salt flower, with an estimated yield of 2 to 3 kg per m², followed by denser crystals, with an average production of 15 to 20 kg per tank per cycle.
Generation and waste brine disposal: It is estimated that approximately 400 to 500 liters of residual brine are discarded per production cycle. This is disposed of through simple drainage channels, built in earthen ditches, in different directions such as the Matola River, the ocean and underground (Figure 1).

Figure 1. Production flowchart at Salinas Golfinho, Lda.
Environmental and social comments
The proximity of the salt pan to residential areas (around 10 meters) represents a potential risk if liquid waste is not properly managed. However, the salt pan is an important source of informal employment for the local population, with around 12 fixed and seasonal workers. The absence of a system for reusing the residual brine represents an opportunity for environmental and technical improvement.
Process and sample collection at Mercado Fajardo
The carrots for this study were purchased at the Fajardo Market, located in the Alto-Maé district of Maputo, one of the busiest markets in the capital. This market is characterized by its commercial diversity, where you can find products from different categories, such as fresh food, condiments, meat, fruit, vegetables, clothing and various utensils, and is considered a strategic point for purchasing fresh vegetables from various regions of the country.
The Fajardo Market was chosen because of its wide supply and high turnover of vegetables, which increases the likelihood of obtaining carrots in good condition and with freshness suitable for the experimental purpose.
As for the selection and purchase criteria, we opted for carrots of national origin, from the southern part of Mozambique, although the seller did not specify the exact place of production in detail. It was guaranteed, however, that the carrots had recently arrived on the market, which suggests a satisfactory level of freshness. The carrots were selected on the basis of a prior sensory evaluation, observing the following parameters:
- Visual appearance: no stains, cuts, bruises or signs of initial putrefaction;
- Touch: firm texture, indicating good post-harvest conservation;
- Aroma: presences of the fresh, characteristic smell of carrots, with no foreign odors or signs of deterioration. The carrots selected had good physical quality and were considered suitable for the experimental lactic fermentation process, thus guaranteeing the reliability of the study's results.
Sample preparation
Brine treatment
The brine used in the process was initially sent to the National Water and Food Hygiene Laboratory, where preliminary physicochemical and microbiological characterization was carried out in order to evaluate its composition. Analyses were carried out to determine total hardness (calcium and magnesium), the presence of nitrates, pH and chlorides (degree of salinity), ensuring prior knowledge of the conditions of the solution to be used in the fermentation process.
Carrot Fermentation Process
After the preliminary laboratory analyses had been carried out, the residual brine was subjected to further treatment to make it suitable for the fermentation process. The brine was first filtered to remove possible impurities and then heat-treated by boiling for 1 hour, with two main objectives: to eliminate contaminating microorganisms, ensuring the sterilization of the solution, and to reduce its volume, thus simulating a more concentrated brine, since the sample had been taken during a rainy period and could have diluted salt levels. The heat treatment therefore made it possible to increase the salt concentration and create a more controlled and safer environment for the spontaneous fermentation of the carrots.
After this treatment, the brine was incorporated into the experimental process of lactic fermentation of the carrots (Figure 2).

Figure 2. Production flowchart for the lactic fermentation of carrots in residual brine.
Raw material preparation: The carrots were washed with running water, without applying any disinfectants or peeling, in order to preserve the natural microbiota on the surface of the vegetable, which is essential for conducting spontaneous fermentation. After washing, the carrots were cut into uniform sticks in order to increase the contact surface with the brine, favoring the fermentation process.
Sterilization of recipients: The glass jars and their metal lids used for filling were sterilized by boiling for 20 minutes, ensuring the elimination of contaminants and avoiding interference in the microbiological process.
Weighing the ingredients: With the jar previously weighed on a scale, the ingredients were weighed: 464 g carrot; 168g distilled water
Brine preparation: The target salt concentration in the final solution was set at 2.5%. For this, two methodological options were considered:
- Option A: Direct addition of solid salt (conventional brine): Calculation: 2.5% of 632 g = 15.8 g of solid salt to be added directly to the flask.
- Option B: Use of concentrated brine (35.5%): The dilution formula C₁V₁ = C₂V₂.
Where:
- C₁ = 35.5% (concentrated brine)
- C₂ = 2.5% (desired concentration)
- V₂ = 168 g (total volume of the liquid part)
- V o V₁ = (2.5 × 168) / 35.5 ≈ 11.8 g of concentrated brine
- Complementary distilled water: 168 g - 11.8 g = 156.2 g
Filling: After preparing the ingredients, the sterilized jars were filled, adding fermentation weights to ensure that the carrots remained completely submerged in the brine, minimizing contact with oxygen and preventing the growth of undesirable microorganisms on the surface.
Sealing and Fermentation Conditions: The lids of the jars were only fitted, without hermetic sealing, allowing the carbon dioxide (CO2) generated during fermentation to flow out naturally. The jars were stored at room temperature, away from direct light, for a period of 15 days (Figure 3).
At the end of the fermentation period, the jars were sent to the National Water and Food Hygiene Laboratory, where mold and yeast were quantified; centesimal analysis (moisture, ash, fat, fiber, calcium, phosphorus, iron, carbohydrates, energy value) and the final pH was determined.

Figure 3. Fermented carrot on day 15.
Laboratory analysis of residual brine
To determine the pH, the electrometric method with a glass electrode was applied.
a) Chloride determination: To determine chlorides, 1 mL of the brine diluted in 99 mL of distilled water was used in an erlenmeyer flask. Then 1 mL of potassium chromate solution (KCrO7) was added as an indicator. The solution was titrated with silver nitrate (AgNO3) until the color changed to brick orange, indicating the end point of the titration, corresponding to the formation of silver chromate.
b) Water hardness: To determine the hardness of the water (calcium and magnesium ion content), 1 mL of the brine was diluted in 49 mL of distilled water. To the solution, 1 mL of ammonia/ammonium buffer was added (to adjust the pH to around 10) and 1 drop of erichrome black indicator T. The solution was titrated with EDTA (ethylenediaminetetraacetic acid). The titration continued until the color changed from wine to blue, indicating the end point.
c) Determination of Qualitative Nitrates: For the Determination of Qualitative Nitrates, 1 mL of the sample and 1 mL of diphenylamine solution (Mesler's reagent) were used. The presence of nitrates is indicated by the formation of an intense blue color, resulting from the oxidation of diphenylamine in an acidic medium in the presence of nitrates. This test only confirms the presence or absence of nitrates and is not used for quantification.
d) Analysis of phosphorus: 5mL of the sample was taken and treated with sulfuric acid for acidification. Ammonium molybdate reagent was then added, which reacts with the phosphates present to form a molybdenum blue complex, the intensity of which is proportional to the phosphorus concentration. It is then read by spectrophotometry at 660 nm and compared with a standard calibration curve prepared with known phosphorus solutions.
Fermented carrot analysis
Molds and yeasts
The sample, previously comminuted in sterile solution, was diluted and decimal dilutions prepared. 1 mL of the sample was pipetted into sterile Petri dishes, the molten culture medium was added at approximately 45°C, mixed and allowed to solidify. It was incubated at 25°C for 72 hours in an inverted position. The colonies were counted and the results expressed in CFU/g or CFU/mL (Figure 4).
Figure 4. Petri dishes, sowing by incorporation.
Physico-chemical analysis of carrots
a) Moisture: To determine moisture, 5 g of the carrot sample was weighed in a Petri dish and placed in a drying oven at 105°C for approximately 3 hours, until the sample was completely dehydrated. After the drying time, the plate was cooled in a desiccator and weighed again. The loss in mass corresponds to the moisture content of the sample.
b) Ash: To determine the ash, after extracting the moisture, 3 g of the dry carrot sample was weighed into a crucible. The sample was first subjected to continuous carbonization for 16 hours in a stove, in order to reduce the organic matter superficially. The crucible was then placed in a muffle furnace at approximately 600°C, where it remained until it was completely incinerated, resulting in a mineral residue. The crucible was then cooled in a desiccator and weighed. The final residue was taken as the ash content of the sample.
c) Lipids: To determine lipids, 2 g of the dried carrot sample was placed in appropriate cartridges and taken to the drying oven for 3 hours to remove residual moisture. The cartridges were then inserted into the lipid extraction machine, where the lipid compounds were extracted. After extraction, the cartridges were dried again for 2 hours in an oven, cooled in a desiccator and weighed. The difference in mass corresponds to the amount of lipids extracted from the sample.
d) Fiber: To determine the fiber content, 3 g of the dried carrot sample was used and subjected to a sequential digestion process. First, the sample was treated with dilute sulfuric acid (1.25%) under heating, to simulate gastric digestion and remove the acid-soluble constituents. The sample was then washed and treated with sodium hydroxide (1.25%), also under heating, to remove the alkaline-soluble compounds, such as proteins and part of the starch. The final residue was filtered, dried in an oven, incinerated in a muffle furnace and the fiber content determined by the difference between the dry residue and the ash obtained after incineration.
e) Calcium: The mineral residue obtained after incinerating the dry carrot sample was used to determine calcium. The ashes were dissolved in dilute hydrochloric acid (HCl), forming a solution containing the minerals present. This solution was then subjected to titration with EDTA, in a buffered medium at pH 10 (usually with ammonia/ammonium buffer), using eriochrome black T as an indicator. The titration was carried out until the color changed, indicating the end point. The amount of EDTA consumed corresponds to the concentration of calcium present in the ash sample.
f) Phosphorus: For the analysis of phosphorus from ash, the mineral residue obtained from incinerating the dried carrot sample was dissolved in dilute hydrochloric acid (HCl) to solubilize the minerals. The resulting solution was then reacted with ammonium molybdate in an acidic medium, forming a phosphomolybdate complex. This complex can then be reduced with ascorbic acid or another reducing agent, giving rise to a characteristic blue color (molybdenum blue), the intensity of which is measured by spectrophotometry at around 660 nm. The phosphorus concentration is determined on the basis of a standard calibration curve, allowing the phosphorus content of the sample's ash to be calculated.
g) Carbohydrates: The determination of the carbohydrate content in foods was generally done by difference, i.e. by subtracting the contents of the other components analyzed (moisture, proteins, lipids, ash and fibre) from the total matter. Each component must be expressed as a percentage (% m/m) of the sample. The calculation formula is:
Carbohydrates (%) = 100 - (Moisture +Proteins + Lipids + Fats + Fibers)
h) Energy: The energy (caloric) value of a food is also calculated based on the sum of the macronutrients - carbohydrates, proteins and lipids - multiplied by their caloric equivalence. The calculation formula used was:
Energy (kcal/100g) = (Carbohydrates x 4) + (Proteins x 4) +(Lipids x 9)
Sensory analysis
The sensory evaluation was carried out with a panel made up of individuals aged between 20 and 30, with an equal distribution between the sexes (50% women and 50% men). The evaluation process was based on the application of a structured questionnaire, available in the appendix, which allowed for the systematic collection of sensory data.
Essential sensory attributes of the fermented product were evaluated, namely color, aroma, flavor, texture and overall appearance, as well as the degree of similarity to a standard product and the level of overall acceptance by the tasters.
The methodology applied was the triangular sensory test, in which the tasters were given three coded samples, two identical and one different. In this case, samples 1 and 3 corresponded to the product fermented with residual brine, the main object of the study, while sample 2 was fermented with conventional brine, used as a comparative reference.
This type of sensory test made it possible to objectively evaluate the differentiation between the products and the sensory preference of the tasters, providing valuable subjective information on consumer perception of the organoleptic characteristics of vegetables fermented with residual brine.
Discussing the results
Physico-chemical parameters of the water
The results of the preliminary physicochemical characterization of the residual brine used in the fermentation process revealed important aspects for understanding its composition and potential technological application. They are shown in the table 1.
Table 1. Physico-chemical parameters of the residual brine
|
Parameter |
pH |
Chlorides |
Hardness (Ca2+ and Mg2+) |
Phosphorus |
Nitrates |
|
Residual brine |
6 |
5% |
290mg/L |
0 mg |
Ausente |
The initial pH of the brine was 6.0, a value considered almost neutral, which is within the expected range for residual brines taken directly from crystallization tanks. This relatively high value can be attributed to the natural dilution of salts by seasonal precipitation, since the sample was taken during the rainy season, a factor that directly interferes with the composition of residual seawater. This characteristic reinforced the need for heat treatment and artificial concentration of the brine by boiling, as adopted in this study, to simulate a more saturated brine suitable for the fermentation process.
The chloride concentration was 5%, which is lower than the usual levels in industrial brines (usually over 10%). This low concentration is also a reflection of the dilution caused by the rains, which, without the concentration treatment, could compromise the salt's inhibitory action on undesirable microorganisms during fermentation. As described by Ray & Sivakumar (2009), salt levels of less than 5% can favor the proliferation of spoilage bacteria and molds. Therefore, heat treatment with volume reduction was a necessary measure to correct this initial condition.
As for the total hardness of the brine, a high value of 290 mg/L of calcium and magnesium was recorded, indicating a brine rich in minerals. These values are consistent with the typical mineral profile of brines from artisanal crystallizers (De Sousa et al., 2021). This hardness can be beneficial in the fermentation process, as calcium ions, in addition to contributing to the structural firmness of vegetables, can also positively influence the enzymatic activity of some lactic acid bacteria (Carbonera & Espírito Santo, 2010; Zhao et al., 2024).
The absence of nitrates and phosphorus in the brine analyzed is also relevant. The absence of nitrates is a positive factor from the point of view of food safety, as these compounds, when present in excess, can be converted into nitrites and pose risks to human health, especially through conversion into nitrites and possible carcinogenic effects (FAO, 2017). The absence of nitrates suggests that the residual brine in this case poses no risk in terms of the presence of undesirable nitrogenous compounds. The absence of phosphorus indicates a limited mineral composition in this specific nutrient, which is compatible with the origin of the brine - a product of seawater evaporation and not organic or agricultural sources.
Characterization of the Fermented Carrot
The pH analysis of the fermented carrot revealed a final value of approximately 3.5, which is completely in line with the principles of spontaneous lactic fermentation and the expected values for this type of product. A pH of less than 4.0 indicates efficiency in the production of lactic acid by lactic acid bacteria, mainly of the Lactobacillus genus, which are naturally present on the surface of vegetables and find in the brine a favorable environment for their development (Zhao et al., 2024).
Lowering the pH represents one of the main natural preservation mechanisms, as it prevents the growth of pathogenic and deteriorating microorganisms, according to Carbonera and Espírito Santo (2010), such as Escherichia coli, Salmonella spp., Listeria monocytogenes and toxigenic molds. Since pH levels below 4.2 are considered safe for fermented vegetable products, they guarantee microbiological stability and extend shelf life without the need for chemical additives.
In addition, the pH value of 3.5 obtained in this study reinforces the good performance of waste brine as a fermentation medium, validating its practical viability. Studies such as those by Lys (2024) show that the use of alternative resources, such as agro-industrial waste or salt-rich wastewater, can be an effective strategy for promoting controlled and safe fermentations.
Mold and yeast count
The results of the microbiological count indicated the absence of molds (0 CFU/g) and the presence of yeasts above 300 CFU/g in the fermented carrots. This absence of molds is a positive indicator, since an acidic environment (pH 3.5) and rapid lactic fermentation create unfavorable conditions for the development of undesirable fungi, guaranteeing the safety of the product in terms of contamination by pathogenic microorganisms (Ray & Sivakumar, 2009).

Figure 5. Petri dishes after incubation, filled with yeast CFUs.
On the other hand, high yeast counts can be interpreted from two perspectives. On the one hand, the presence of yeasts can contribute to the complexity of the sensory profile, favoring the formation of volatile compounds that enrich the aroma and flavor of the fermented product (Kim & Park, 2015). On the other hand, this high population raises the hypothesis of parallel alcoholic fermentation, in which part of the sugars may be converted into ethanol and carbon dioxide, which in some cases may be undesirable if ethanol levels exceed acceptable limits for human consumption (Zhao et al., 2024).
Carrot physicochemical parameters
The centesimal analysis showed marked changes in the nutritional composition of the carrot after fermentation with residual brine (table 2).
Table 2. Chemical physical parameters of carrots
|
Parameter |
Unfermented carrots |
Carrot after fermentation with residual brine |
|
Humidity (%) |
90,0 |
92,0 |
|
Chestnut (%) |
0,7 |
1,1 |
|
Fibers (%) |
2,5 |
2,8 |
|
Lipids (%) |
0,2 |
0,3 |
|
Proteins (%) |
1,0 |
0,9 |
|
Carbohydrates (%) |
5,6 |
2,9 |
|
Energy (kcal) |
26,0 |
17,3 |
|
Calcium (mg/100g) |
33 |
48 |
|
Phosphorus (mg/100g) |
30 |
23 |
Moisture, for example, went from 90% in the raw carrot to 92% in the fermented one, which can be explained by the absorption of water and salts during the fermentation process, corroborating the findings of Janiszewska-Turak et al. (2023), who observed a similar behavior in vegetable juices undergoing fermentation.
The increase in the percentage of ash, from 0.7% to 1.1%, indicates the transfer of minerals present in the residual brine to the carrot matrix, potentially enriching the food with essential micronutrients. This mineral enrichment was evidenced by the increase in the calcium content (from 33 to 48 mg/100g), however the same is not true for phosphorus (from 30 to 23 mg/100g), which suggests a small loss or dissolution of this mineral into the brine, which previously did not have it in its composition (Zhao et al., 2024; Lys, 2024).
The reduction in carbohydrates, from 5.6% to 2.9%, reflects the consumption of sugars by lactic acid bacteria during fermentation, a process which results in the production of lactic acid and other metabolites (Kim & Park, 2015). This decrease in carbohydrates also contributed to the reduction in energy value, which went from 26 kcal to 17.3 kcal per 100g, in line with the principle that fermentation tends to reduce the calorie content of vegetables by consuming the available sugars (FAO, 2017).

Figure 6. Comparison of the centesimal analysis of fermented and unfermented carrots.
A slight reduction in the protein content (from 1.0% to 0.9%) was also suggested, under the hypothesis of the action of enzymes released during fermentation, which can degrade proteins into smaller peptides or amino acids, without significantly affecting the overall nutritional value of the food. In contrast, it was observed that lipids remained practically unchanged, since lactic fermentation is not characterized by the use of fats as the main substrate.
The relative increase in fiber (from 2.5% to 2.8%) can be attributed to the concentration of solids remaining after the consumption of soluble carbohydrates, as well as possible structural modifications to the cell wall promoted by the fermentation process (Ray & Sivakumar, 2009; Kim & Park, 2015). This phenomenon suggests that although fermentation consumes soluble components, it can simultaneously enhance the insoluble fraction, potentially improving the digestibility and functionality of the fibers present.
These changes in nutritional composition indicate that fermentation using residual brine not only transforms carrots into a product with a lower caloric value, but also enriches them with minerals and fiber, attributes that can contribute to the promotion of a healthy and functional diet (Arscott & Tanumihardjo, 2010; Ikram et al.,2024). In addition, the reduction in carbohydrates and the subsequent increase in acidity can favor the preservation of the food, extending its shelf life and improving its microbiological safety.
Sensory analysis
In general, Samples 1 and 3 (fermented with residual brine) scored higher on the various attributes than Sample 2 (fermented with conventional brine) (Table 3).
Table 3. Sensory analysis results
|
Attribute residual brine (sample 1) |
Residual brine (sample 1) |
Conventional brine (sample 2) |
Residual brine (sample 3) |
|
Color |
7,6 |
6,8 |
7,4 |
|
Aroma |
7,2 |
6,5 |
7,2 |
|
Taste |
6,8 |
6,2 |
7,0 |
|
Texture |
7,4 |
6,6 |
7,2 |
|
Appearance |
7,3 |
6,4 |
7,5 |
|
Acceptance |
7,5 |
6,6 |
7,4 |
The average scores for attributes such as color (7.6), aroma (7.2), taste (6.8 to 7.0), texture (7.2 to 7.4) and overall acceptance (7.4 to 7.5) indicate a satisfactory sensory perception, falling within the ranges interpreted as “I liked it moderately” to “I liked it very much”, according to the hedonic scale.
One of the most important points observed was that 75% of the tasters reported that the flavor and aroma of the vegetables fermented with residual brine were remarkably similar to the typical sensory profile of olives, particularly in the descriptors of mild acidity, balanced saltiness and slightly fermented aroma. This observation is consistent with studies described in the literature, such as in the Noma Guide to Fermentation (Kim & Park, 2015; Ray & Sivakumar, 2009), which indicate that lactic fermentation can confer complex organoleptic notes and ripeness characteristics similar to those of traditional fermented products such as olives, pickles and sauerkraut.
The perception of this similarity to the sensory profile of olives is a positive aspect, as it reinforces the familiar and acceptable nature of the product with consumers, and can be exploited commercially a sensory differential.

Figure 7. Comparison of Sensory Analysis Results - Residual vs. Conventional Brine.
As for the preference declared by the tasters, it was found that the majority chose Samples 1 and 3 as their favorites, indicating sensory acceptance similar to or greater than that of the sample with conventional brine, which demonstrates the sensory viability of using residual brine in the lactic fermentation process.
Conclusions
The results obtained in this study show that the residual brine from the production of sea salt at Salinas Golfinho, Lda has viable potential as an alternative medium for the lactic fermentation of carrots (Daucus carota L.), proving to be a functional, sustainable and economically accessible solution. Its application has enabled not only the valorization of an often discarded by-product with an environmental impact, but also the production of a safe, nutritionally enriched and sensorially attractive fermented food.
The decrease in the final pH to between 3.5 and 3.9, together with the absence of molds and significant yeast growth, showed the effectiveness of the residual brine in promoting an environment conducive to spontaneous fermentation, even in the absence of nutrients such as phosphorus and nitrates. Centesimal analysis revealed significant improvements in fiber, ash, calcium and phosphorus content, with a consequent reduction in carbohydrates and energy value, making the final product healthier and more functional.
In addition, the positive sensory acceptability reinforces the potential of this process for domestic, agro-industrial or community use, standing out as a viable alternative for vegetable preservation, food diversification and combating waste. The application of residual brine in the context of the circular economy is strategic, integrating sustainability practices and technological innovation in the agri-food sector.
It can therefore be concluded that the use of residual brine as a fermentation medium not only contributes to reducing environmental impacts, but also promotes the development of new products with added value, with the potential to be replicated in different production contexts, especially in communities with limited resources. For future work, we recommend replicating the technique with other vegetables and analyzing their microbiological behavior under different storage conditions.
References
Abbaspour, N. (2024). El papel fundamental de la fermentación en la conformación del futuro de los alimentos de origen vegetal: una revisión integradora de los procesos de fermentación y su impacto en los beneficios sensoriales y para la salud. Applied Food Reserach, 4(2). https://doi.org/10.1016/j.afres.2024.100468
Arscott, S.A., & Tanumihardjo, S.A. (2010). Carrots of many colors provide basic nutrition and bioavailable phytochemicals acting as a functional food. Comprehensive Reviews in Food Science and Food Safety, 9(2), 223–239. https://doi.org/10.1111/j.1541-4337.2009.00103.x
Boccato, V.R.C. (2006). Metodologia da pesquisa bibliográfica na área odontológica e o artigo científico como forma de comunicação. Revista de Odontologia da Universidade de São Paulo, 18(3), 265–274. https://pesquisa.bvsalud.org/odontología/resource/espt/lil-488641
Carbonera, N., & Espírito Santo, M.L.P. (2020). Actividade do Lactobacillus plantarum na preservação da anchoita (Engraulis anchoita) fermentada. Revista Instituto Adolfo Lutz, 69(2), 201–207. https://docs.bvsalud.org/biblioref/ses.sp/2010/ses-17983/ses-17983-1818.pdf
De Sousa, C.H., da Silva Costa, L., Carbonera, N., & Helbing. E. (2021). Propiedades tecnológicas de bactérias ácido-lácticas em lacticínios: Revisao. Revista do Instituto de Lacticínicos Cándido Tostes, 76(4), 243-256. https://doi.org/10.14295/22238-6416.v76i4.861
Didari, T., Solki, S., Mozaffari, S., Nikfar, S., & Abdollahi, M. (2014). Una revisión sistemática de la seguridad de los probióticos. Opinión de expertos sobre seguridad de fármacos, 13(2), 227-239. https://doi.org/10.1517/14740338.2014.872627
FAO. (2017). Human vitamin and mineral requirements: Report of a Joint FAO/WHO Expert Consultation, Bangkok, Thailand. Food and Agriculture Organization. https://www.fao.org/4/y2809e/y2809e/y2809e00.htm
Fernández-Xicoten, R.I., Loria Maen, J.J., Medina Amta, I., & Makita Balcorta, T.G. (2023). Desperdicio de aliments desde la persppectiva de los colaboradores del sector hotelero en Cancún, Quintana Roo. Estudios sociales. Revista de alimentación contemporánea y desarrollo regional, 33(62). https://doi.org/10.24836/es.v33i62.1384
Gil, A. C. (2008). Métodos e técnicas de pesquisa social. Atlas.
Huang, J., Wang, J., & Liu, S. (2023). Advanced fermentation techniques for lactic acid production from agricultural waste. Fermentation, 9(8), 765. https://doi.org/10.3390/fermentation9080765
Ikram, A., Rasheed, A., Ahmad Khan, A., Khan, R., Ahmad, M., Bashir, R. & Hassan Mohamed, M. (2024). Exploring the health benefits and utility of carrots and carrot pomace: a systematic review. International Journal of Food Properties, 27(1), 180-193. https://doi.org/10.1080/10942912,2023.2301569
Janiszewska-Turak, E., Pobiega, K., Rybak, K., Synowiec, A., Woźniak, L., Trych, U., Gniewosz, M., & Witrowa-Rajchert, D. (2023). Changes in physical and chemical parameters of beetroot and carrot juices obtained by lactic fermentation. Applied Sciences, 13(10). https://doi.org/10.20944/preprints202304.1183.v1
Katz, S. E. & Tanguy, E. (2023). The art of fermentation: An in-depth exploration of essential concepts and processes from around the world. Alaúde.
Kaur, C., & Kapoor, H. (2017). Antioxidant activity and total phenolic content of some important fruits. Food Chemistry, 67(3), 307–314. https://scirp.org/reference/referencespapers?referenceid=107274
Kim, S., & Park, E. J. (2015). Fermentation characteristics of Shindari added with carrot. Korean Journal of Food and Cookery Science, 31(1), 9–17. https://doi.org/10.9724/kfcs.2015.31.1.009
Lys, I. (2024). The role of lactic fermentation in ensuring the safety and extending the shelf life of African indigenous vegetables and its economic potential. Applied Research, 4. https://doi.org/10.1002/appl.202400131
Marconi, M. A., & Lakatos, E. M. (2017). Fundamentos de metodologia científica. Atlas.
Ray, R. C., & Sivakumar, V. (2009). Lactic acid bacteria and their applications in food preservation and production. In R. C. Ray & V. Sivakumar (Eds.), Microorganisms in foods: Preservation and applications. Springer.
Sharma, K. D., Karki, S., Thakur, N. S., & Attri, S. (2015). Chemical composition, functional properties and processing of carrot. A review. Journal of Food Science and Technology, 49(1), 22–32.
Valentino, V., Magliulo, R., Farsi, D., Cotter, P.D., O´Sullivan, O., Ercolini, D., & De Filippis, F. (2024). Alimentos fermentados, su microbioma y su potencial para mejorar la salud humana. Biotecnología microbiana, 17(2). https://doi.org/10.1111/1751-7915.14428
Zapasnik, A., Sokolowska, B., & Bryla, M. (2022). Papel de las bacterias del ácido láctico en la conservación y seguridad de los alimentos. Alimentos, 11(9), 1283. https://doi.org/10.3390/foods11091283
Zhao, J., Zeng, X., Xi, Y., & Li, J. (2024). Recent advances in the applications of Lactobacillus helveticus in the fermentation of plant-based beverages: A review. Trends in Food Science & Technology, 147, 574–582. https://doi.org/10.16/j.tifs.2024.104427